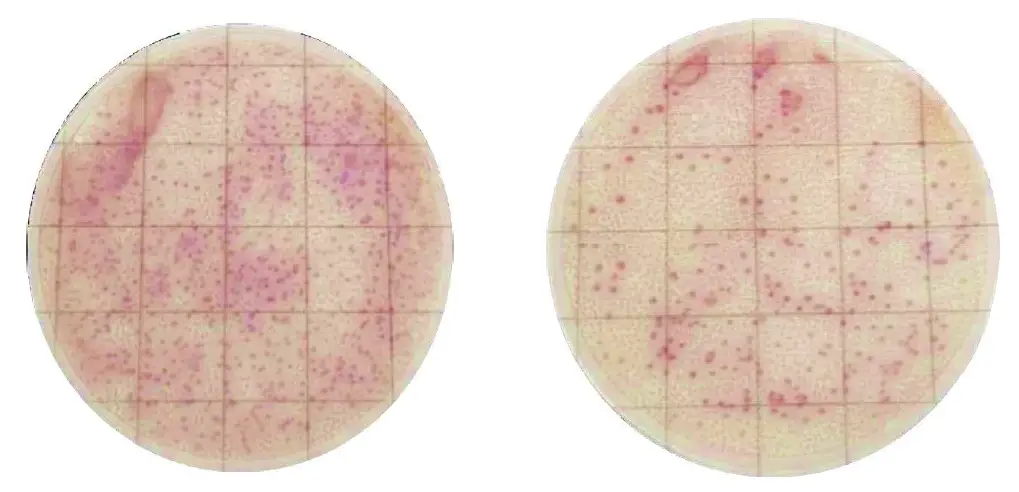
MicroFast-MF1006-Salmonella-Count-Plate-FIG-1 (2)

MicroFast MF1006 Salmonella Count Plate
Product Information
Part #: MF1006
The product is a testing kit designed to detect Salmonella in samples. It provides accurate results when used correctly. Scigiene is the manufacturer of the product and can be contacted for any issues or inquiries. Please note that the use of the product is subject to certain limitations and Scigiene’s liability is limited as stated in theuser manual.Users are responsible for familiarizing themselves with the product instructions and information. External factors can affect the results, so it is important to choose the appropriate test method and ensure that it meets the user’s criteria.Results obtained from the use of the product cannot guaranteethe quality of the tested matrices or processes.
Product Usage Instructions
Sample Preparation
- Mix the appropriate amount of test samples with buffer solution according to the standard requirements to obtain a sample solution (1:10).
- Transfer 1mL of the homogenized solution to a tube containing 9mL of diluting buffer (sterile saline solution or PBS buffer) to obtain a 1:100 sample solution. Repeat this step to obtain a 1:1000 sample solution.
- Choose 2 or 3 diluted sample solutions with a suitable concentration gradient for the inoculation test. For liquid samples, the initial sample can be used for inoculation.
Operation Procedure
- Open the aluminum foil bag and take out the plates.
- Place the plate on a horizontal worktable. Lift the top film using thumbs and forefingers while pressing the other fingers onthe top label of the plate (avoid touching the culture area).
- Pipette 1mL of the sample solution and drop it vertically onto the center of the plate.
- Cover the top film slowly and the solution will spread automatically. Do not move the plate until the solution spreads completely (approximately 1 minute).
Incubation
After incubation, Salmonella colonies will appear pink on the count plate, while non-Salmonella colonies will be blue, yellow, white, or may not grow. Use a standard colony counter or illuminated magnifier to visually count suspected colonies. The culture time can be extended if needed for better interpretation.
Storage
- When unopened, store the product at a temperature between 2-8°C and use it within the specified shelf life.
- In a high-humidity environment, allow the test piece to return to room temperature before use.
- After unsealing, fold the aluminum foil bag twice and seal it with adhesive tape or a suitable sealant.
Introduction
MicroFast® Salmonella Count Plate (SAL) is a sample-ready-culture medium system that contains improved media, a cold-water-soluble gelling agent, and an indicator that facilitates colony enumeration. It is intended for Salmonella tests in the environment and food.
WARNINGS & PRECAUTIONS
- The user should read, understand, and follow all safety information in the instructions before use.
- The MicroFast Count Plate should be disposed following procedures for infectious or potentially infectious products. User should wear appropriate personal protective equipment, including, but not limited to, protective disposable gloves, laboratory coats, and eye protection when handling samples and kit reagents, Wash hands thoroughly after handling specimens and reagents. It is the responsibility of each laboratory to handle waste and effluents produced according to their type and degree of hazardousness and to treat and dispose of them (or have them treated and disposed) in accordance with local, state, and federal regulations. Strict compliance with BSL-2 practices should be followed.
- Follow all product storage guidelines included in the insert. Do not use after the expiration date.
- MicroFast Count Plate testing should be done in a professionally equipped laboratory under the supervision of a skilled microbiologist. The user must train its staff on the current testing methods.
- MicroFast Count Plates have not been reported for application in industries other than food and environmental samples. Use within the suggested scope.
- Counting results of MicroFast Count Plates may not be the same as agar.
- MicroFast Count Plate have not been evaluated with all possible food products, food processes, testing protocols or with all possible microorganism strains.
- As a general precaution, clean the workstations with the disinfectant of choice (e.g., sodium hypochlorite solution, phenol solution, quaternary ammonium solution) before and after, in addition to having work areas separated for the following: media preparation, sample preparation, and indicator organism enumeration. Gloves and other personal protective equipment should always be used.
- Count plate may contain microorganisms that may be a potential biohazard. Follow current industry standards for disposal.
- Keep the count plate away from ultraviolet, direct sunlight and fluorescent lamp.
- Do not use the polluted or damped count plate.
- If the pH of the test sample is too high or too low, it will affect the accuracy of the test results.
- When uncovering the film, do not touch the culture area of the medium.
- If there are too many colonies, the detection of positive strains might be affected.
- The count plate may show a few needle-like black spots, which is normal and does not affect the interpretation of the target strain.
- If the sample is viscous, diffusion can be aided manually.
- When pipetting samples, do not touch culture area.
Limitation of Warranties
Accurate results depend on the proper use of the kit by following the instructions for use carefully. If the kit fails to perform according to specification, please contact Scigiene
Limitation of Scigiene Liability
Scigiene will not be liable for any loss or damages, whether direct, indirect, special, incidental or consequential damages, including but not limited to lost profits. In no event shall Scigiene’s liability under any legal theory exceed the purchase price of the product alleged to be defective.
User Responsibility
Users are responsible for becoming acquainted with product instructions and information. For further information, please contact Scigiene.
When choosing a test method, please note that external factors such as sampling methods, testing protocols, sample preparation, handling, and laboratory technique can all have an impact on the results.
When selecting a test method or product, it is the user’s duty to assess a sufficient number of samples with the proper matrices and microbiological challenges to ensure that the chosen test methos meets the user’s criteria. It is also the user’s obligation to ensure that any test methods and results fulfill the criteria of its customers/suppliers.
Results acquired from the use of any Scigiene product, like any other method, cannot guarantee the quality of the tested matrices or processes.
Sample Preparation
- The appropriate amount of test samples will be mixed with buffer solution according to the standard requirements and get the sample solution (1:10).
- Transfer 1mL of homogenized solution (from step 1) to a tube containing 9mL of diluting buffer (sterile saline solution or PBS buffer), then get the 1:100 sample solution. And so on for the 1:1000.
- Choose 2 or 3 diluted sample solutions with a suitable concentration gradient for the inoculation test (As for liquid samples, the initial sample can be used for inoculation).
Operation Procedure
- Open the aluminum foil bag and take out the plates.
- Put the plate on a horizontal worktable; lift the top film by thumbs and forefingers and the other fingers press on the top label of the plate (Don’t touch the culture area).
- Pipette 1mL of sample solution and drop it to the center of the plate vertically.
- Cover the top film slowly and the solution will spread automatically. It is not necessary to press the film (Don’t move the plate before the solution spreads completely. It takes about 1 min).
Incubation
Incubate MicroFast plates in a horizontal position with the film upwards in stacks of no more than 20. Culture at 36±1℃ for 24±2 h.
Results
After incubation, Salmonella will show pink colonies after growing on the count plate, non-Salmonella will be blue, yellow, and white or, will not grow. Count visually with a standard colony counter or another illuminated magnifier for suspected colonies, the culture time can be appropriately extended to facilitate the interpretation.
Storage
- When unopened, the best storage temperature is 2-8 ℃, and it is used up within the shelf life.
- In a high-humidity environment, please restore the test piece to room temperature before use.
- After unsealing, it is necessary to fold the aluminum foil bag twice, then stick it with adhesive tape or seal it with a sealing clip, store it in the dark at 2-8 ℃, and use it up within one month.
- When transporting or short-term storage, just leave the count plate at room temperature.
CONTACT
- 1295 Morningside Avenue, Unit 16-18
- Scarborough, ON M1B 4Z4 Canada
- Phone: 416-261-4865
- Fax: 416-261-7879
- www.scigiene.com.





















